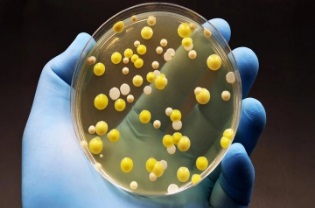

شرایط دریاچه ارومیه پایدار نیست

دریاچه ارومیه در شمال غرب ایران قرار دارد و بزرگترین و شورترین دریاچه دائمی ایران است. این دریاچه از بزرگترین دریاچههای فوق شور و دائمی در جهان نیز است. بارندگی و جاری شدن آب رودخانههای مختلف، منابع اصلی آب ورودی دریاچه ارومیه هستند.
عوامل اقلیمی مثل کاهش بارندگی و افزایش دما، سرعت تبخیر در این منطقه را افزایش داده است. همچنین عوامل انسانی مانند گسترش زمینهای کشاورزی و افزایش تقاضای آب برای آن، بهینه نبودن روشهای آبیاری و اتلاف آب در بخش کشاورزی، احداث سد و کاهش آب ورودی به دریاچه، باعث شده که دریاچه ارومیه متحمل دو دهه خشکی شود. بررسیهای مختلف تایید کرده که مداخله انسان عامل مهمتری در به وجود آمدن چنین شرایطی است. در خطر گرفتن دریاچه ارومیه باعث شد دولت در سال ۹۲ برنامهای ۱۰ ساله برای احیای دریاچه ارومیه تدوین کند و سطح اکولوژیکی آب دریاچه را به میزان ۱۲۷۴/۶۷ متر برساند.
اگرچه تلاشهای بیشماری برای بررسی دلایل خشکی دریاچه صورت گرفته است، اما مطالعات بسیار اندکی وضعیت دریاچه را پس از شروع تلاشهای احیا ارزیابی کردهاند. به همین خاطر پیمان صائمیان و امید علمی به همراه همکارانشان در انستیتو زمینسنجی دانشگاه اشتوتگارت آلمان و دانشکده علوم جغرافیایی دانشگاه بریستول انگلیس، پژوهشی را در خصوص روند پیشرفت احیای دریاچه ارومیه انجام دادند.

در این پژوهش با استفاده از مشاهدات ماهوارهای و اندازهگیری دادههای مختلف مثل سطح آب، مساحت و حجم آب دریاچه، بررسی میزان تبخیر و بارندگی منطقه و… بررسی شد.
به گفته پژوهشگران این مطالعه: «دریاچه ارومیه از سال ۲۰۱۵ تا ۲۰۱۹ تثبیت شده است و روند مثبتی در تراز سطح آب (۱۴/۵سانتیمتر در سال)، مساحت دریاچه (۲۰۴ کیلومتر مربع در سال) و حجم آب (۰/۴۲ کیلومتر مکعب) داشته است».
مشاهدات این محققان تایید کرد که به جز سال ۲۰۱۷ (دو ماه با خشکسالی متوسط) و ۲۰۱۶ (به نسبت مرطوب)، همه سالها مطابق با اقلیمشناسی بلند مدت حوضه آبریز بوده است. با این حال حوضه آبریز در بهار ۲۰۱۹ آب زیادی از باران شدید دریافت کرده است. تجربه چنین دورهای بدون خشکسالی از سال ۲۰۱۵ تا ۲۰۱۹ به توقف کوچک شدن دریاچه و رفتن آن به سمت مرحله احیا، کمک چشمگیری کرده است.
همچنین تعادل آب دریاچه ارومیه نشان میدهد که حدود ۸۰ درصد افزایش حجم آب دریاچه از سال ۲۰۱۵ ناشی از روند مثبت جریان ورودی رودخانهها و مخازن است و ۲۰ درصد باقیمانده به دلیل افزایش یافتن میزان بارش به خود دریاچه بوده است.
روند مثبت آبگیری ۰/۴۵ کیلومتر مکعب در سال در یک طرف و روند مثبت حجم آب دریاچه در سمت دیگر، نشان میدهد که دریاچه از بخش قابل توجهی از آب بهرهمند شده است که برای اهداف کشاورزی استفاده نشده، و به جای آن به دریاچه رها شده است.
بررسیها نشان داد که ذخیره آب از سال ۲۰۱۵ تا پایان سال ۲۰۱۷ کاهش قابل توجهی نداشته و از سال ۲۰۱۵ روی هم رفته، ۱/۷±۷/۲ میلیمتر افزایش یافته است. شرایط جدید ذخیره و شار آب حوضه ارومیه با شرایط حوالی سالهای ۲۰۱۰ تا ۲۰۱۲ قابل مقایسه است.
محققان تاکید کردند با توجه به روند بارش، مساحت دریاچه، آب ورودی به دریاچه و تبخیر از حوضه آبریز، مرحله اول برنامه احیا با هزینه رهاسازی آب از مخازن انجام شده است.
به گفته پژوهشگران: «به نظر میرسد که تثبیت شکننده است، چرا که بیشتر افزایش حجم آب دریاچه در منطقه کم عمق جنوب که در فصلهای گرم پتانسیل تبخیر زیادی دارند، پخش شده است. علاوه بر این، به دلیل همبستگی زیاد بین سطح آب دریاچه و میزان بارش، مرحله بهبودی مشاهده شده در سال ۲۰۱۶ و نیمه اول سال ۲۰۱۹ ممکن است در صورت دوره خشکسالی طولانیتر، ادامه نداشته باشد».

برای دستیابی به یک احیای پایدار، نیاز به تلاشهای بیشماری مثل جلوگیری از انحراف جریان آب دریاچه به سمت زمینهای کشاورزی است. نتیجه این پژوهش نشان داد که دریاچه ارومیه با یک روند عمدتا مثبت در جریانهای ورودی، به دلیل بارندگی شدید در سال ۹۸ (۲۰۱۹ میلادی)، تثبیت شده است و بیم آن وجود دارد که با خشکسالی در سالهای آینده این روند معکوس شود.
نتایج این پژوهش در آخرین شماره نشریه Science of the Total Environment منتشر شده است.
منبع:ایسنا